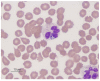
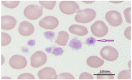
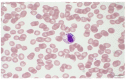

Epidemiology, Diagnosis, and Control of Canine Infectious Cyclic Thrombocytopenia and Granulocytic Anaplasmosis: Emerging Diseases of Veterinary and Public Health Significance
- PMID: 34941839
- PMCID: PMC8705095
- DOI: 10.3390/vetsci8120312
Epidemiology, Diagnosis, and Control of Canine Infectious Cyclic Thrombocytopenia and Granulocytic Anaplasmosis: Emerging Diseases of Veterinary and Public Health Significance
Abstract
This review highlights the diagnostic methods used, the control strategies adopted, and the global epidemiological status of canine cyclic thrombocytopenia and granulocytic anaplasmosis at the animal-human interface. Canine anaplasmosis is an important worldwide disease, mainly caused by Anaplasma platys and A. phagocytophilum with zoonotic implications. A. platys chiefly infects platelets in canids, while A. phagocytophilum is the most common zoonotic pathogen infecting neutrophils of various vertebrate hosts. Diagnosis is based on the identification of clinical signs, the recognition of intracellular inclusions observed by microscopic observation of stained blood smear, and/or methods detecting antibodies or nucleic acids, although DNA sequencing is usually required to confirm the pathogenic strain. Serological cross-reactivity is the main problem in serodiagnosis. Prevalence varies from area to area depending on tick exposure. Tetracyclines are significant drugs for human and animal anaplasmosis. No universal vaccine is yet available that protects against diverse geographic strains. The control of canine anaplasmosis therefore relies on the detection of vectors/reservoirs, control of tick vectors, and prevention of iatrogenic/mechanical transmission. The control strategies for human anaplasmosis include reducing high-risk tick contact activities (such as gardening and hiking), careful blood transfusion, by passing immunosuppression, recognizing, and control of reservoirs/vectors.
Keywords: Anaplasma phagocytophilum; Anaplasma platys; canine anaplasmosis; control; diagnosis; epidemiology.
Conflict of interest statement
The authors declare that the research was conducted in the absence of any commercial or financial relationships that could be construed as a potential conflict of interest.
Figures

References
Publication types
LinkOut - more resources
Full Text Sources